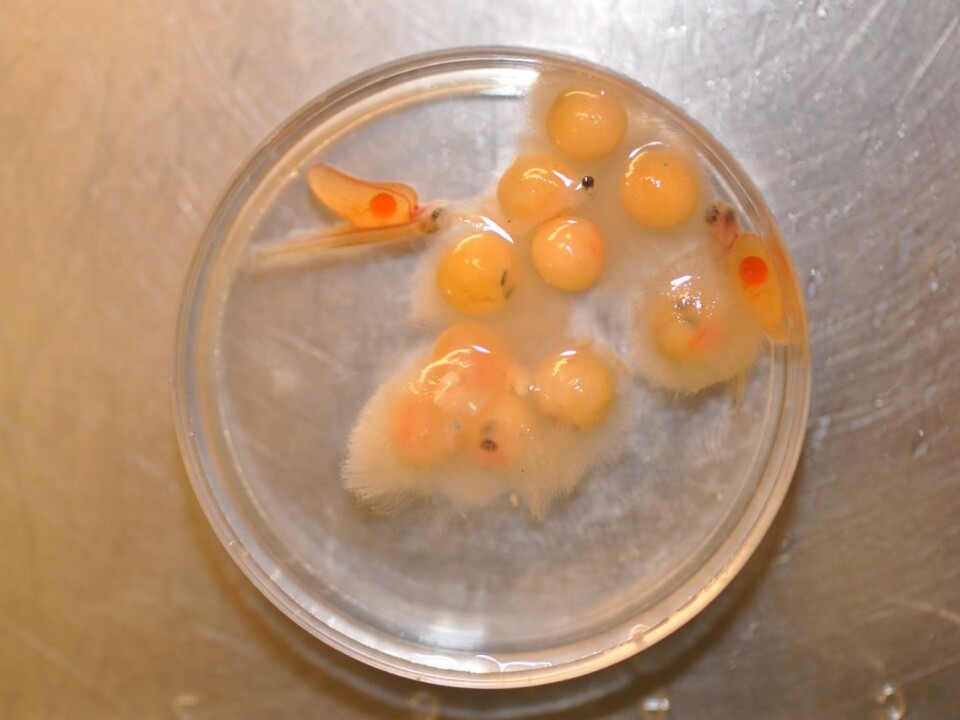

This article was produced and financed by The Norwegian Veterinary Institute

Clustering fish serial killer
It strangles its victims - slowly. Despite treatments, the microorganism Saprolegnia are a recurring problem for fish hatcheries and fry production over the world, causing considerable losses.
Denne artikkelen er over ti år gammel og kan inneholde utdatert informasjon.
Once you have had this problem it seems difficult to get rid of. On average, the industry has a 10 percent loss of fish eggs and fry due to this freshwater mold. Up to 90 percent loss has been recorded in some hatcheries.
New treatment, less effective
Although treating the moldlike growth, the infections comes back again and again. Previously, malachite used to combat Saprolegnia. This drug had a good effect, but was forbidden to use after it proved itself carcinogenic.
New treatment drugs have been introduced, but these have not proven to be as effective, unfortunately.
"We suspect that the repeated infections in hatcheries are due to a reservoir of Saprolegnia that today’s treatment agents are not effective against. Biofilm can be such a reservoir, but we did not know to what extent Saprolegnia was able to form biofilms. Therefore, we investigated this," says Ali Shimaa, research fellow at the Norwegian Veterinary Institute.
"Micro-organisms that form biofilms are often very difficult to combat. Biofilm formation can be seen as a strategy microorganisms often choose to survive in hostile environments. When the Saprolegnia merge and form complex societies with other micro-organisms, the microorganisms become stronger and able to withstand attacks from outside treats, including disinfectants," she continues.
Such microorganisms in clusters produce a protective “skin” or film, so-called matrix that acts as a shield against enemy attacks.
Ability to form biofilms revealed
Not everyone is equally good at forming biofilms and no one has previously examined whether Saprolegnia species can form such micro-organism communities. In this study, they have examined and tested whether Saprolegenia can form such biofilms in both isolated form and in naturally environments where they belong.
"Previously we thought that the deadly Saprolegnia parasitica relied on fish to reproduce similar to virus in that it needs a host cell to reproduce. In earlier studies we have measured the spores of the fungus in the inlet and outlet water from the hatchery facility. This revealed that the spores amount were higher in the outlet water.

The perception has been that it was the fish that made this proliferation possible. The reseachers were therefore surprised when the study revealed that Saprolegnia parasitica both form biofilm and multiply itself asexually, without fish present.
They also found similar variation of Saprolegnia australis. It is therefore likely that natural biofilms serve as reservoirs for Saprolegnia in the wild and in aquaculture.
"This knowledge is essential for developing a new control strategy for the future," she says.
Tested resistance
The study tested various chemicals used to combat and control of Saprolegnia on Saprolegnia biofilms. The experiments showed that despite repeated treatments, Saprolegnia grew up again.
Treatments used today are expensive and not beneficial to the environment. Formalin is one of the substances currently used, but this is banned in more and more countries.
"Therefore it is important to find new ways to combat this killer-mold," Shimaa says.
"We are now working on new strategies for combating Saprolegnia biofilm, among them the possibility of use of functionalized nanomaterials.